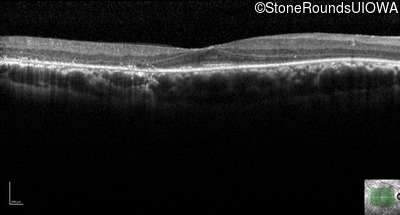
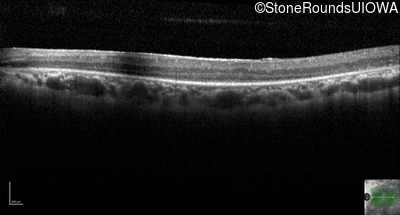
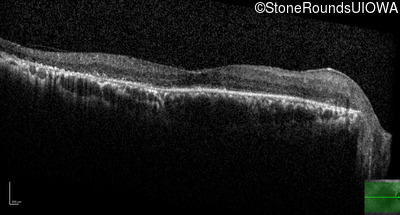
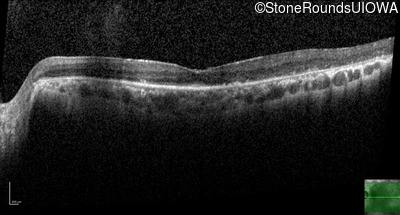
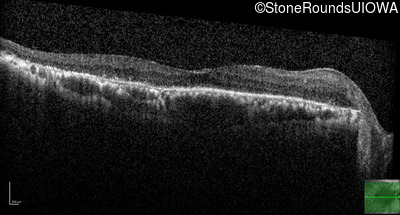
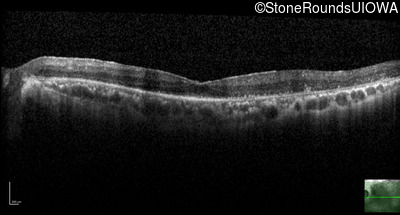
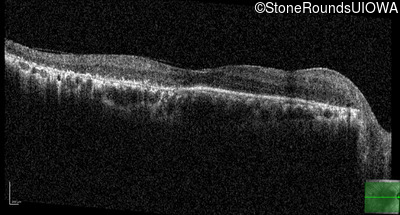
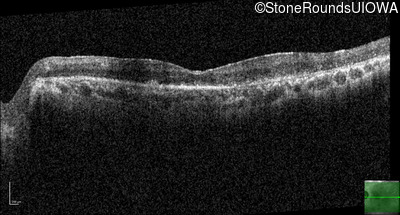

Case
SR2712
Student Mode
AR Retinitis Pigmentosa (IA1aiii)
Male
Male
Hidden
SR2712
Student Mode
AR Retinitis Pigmentosa (IA1aiii)
Male
Male
History
This 62 year old man had poor night vision as a teenager and developed difficulty with his peripheral vision in his early forties. His parents both grew up in the small village in Taiwan.
| Age at visit: 62 years |
| Age at visit: 71 years |
| Age at visit: 73 years |
Diagnosis & molecular findings
| Disease | Gene | Allele 1 variant(s) | Allele 2 variant(s) | Inheritance mode |
|---|---|---|---|---|
| AR Retinitis Pigmentosa | EYS | Cys2139Tyr TGT>TAT | Cys2139Tyr TGT>TAT | AR |
Disease:
Gene:
Allele 1:
Cys2139Tyr TGT>TAT
Allele 2:
Cys2139Tyr TGT>TAT
Inheritance:
AR